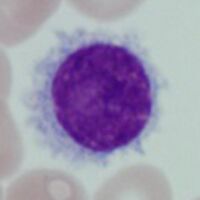

Flow cytometry: Hairy Cell Leukaemia
From haematologyetc.co.uk
Background to flow cytometric diagnosis
HCL expresses typical and unusual markers that together with morphology can allow diagnosed with some confidence using flow cytometry.
However, no marker is unique to HCL and unusual marker patterns can lead to diagnostic difficulty. If this is the case then the atypical features should be reported, since histopathology and molecular testing can each be used to further evaluate these cases.
| Immunophenotype of HCL | |||
|---|---|---|---|
| CD45 expression | |||
| Typically expression of CD45 is high in HCL and is often gretaer than normal T and B cells. | |||
| Major markers useful in diagnosis | |||
| Marker | Freq | Level | Comment |
| κ/λ | Stg | Expect strong restricted expression of κ or λ | |
| CD19 | - | Expression is expected and may be strong in HCL | |
| CD11C | Stg | Strong expression of CD11c is typical of HCL | |
| CD25 | wk | A typical and most frequently strongly expressed marker | |
| FMC7 | Stg | Typically this marker is strongly expressed | |
| CD103 | - | A characteristic marker of HCL with good specificity | |
| Other useful markers | |||
| CD5 | - | Infrequent but reported in some cases | |
| CD10 | - | Infrequently expressed in typical HCL | |
| CD20 | Stg | Expression is expected, and typically strong | |
| CD23 | - | Expression of CD23 is infrequent in HCL | |
| CD38 | wk | Not typically expressed by HCL, may be seen | |
| CD43 | - | Tends to be expressed at relatively high intensity | |
| CD79b | wk | Expression is expected | |
| CD138 | - | Predominantly by cells with plasma cell differentiation | |
| CD200 | - | Characteristically positive in HCL and often strong | |
Key to table:
Key to colour code for expression frequency Click for link
Key to expression strength code and use Click for link